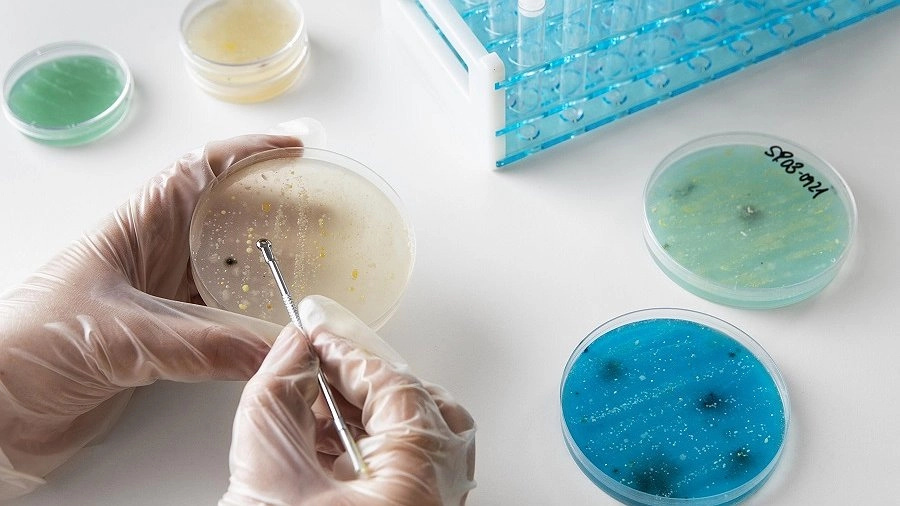

По данным регионального управления Роспотребнадзора по Нижегородской области, с начала текущего года зафиксировано 7666 случаев присасывания клещей к людям.
Источник фото: Фото: freepik
В регионе зарегистрировано 68 случаев заболевания иксодовым клещевым боррелиозом. В связи с этим 1234 человека, включая 1182 ребенка, получили экстренную профилактику. К сожалению, выявлено также 4 случая заражения клещевым энцефалитом.
Всего в лабораториях было исследовано 7666 клещей, из которых в 1370 случаях были обнаружены возбудители различных заболеваний.




